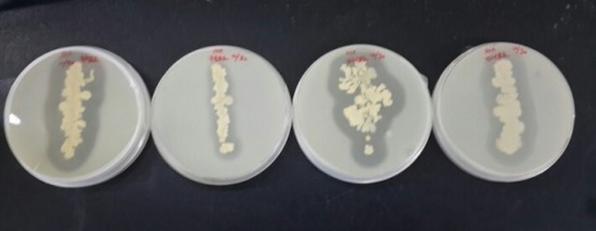
16c4412393beeb7f4a80401b96748d09_1451887394_25.JPG 16c4412393beeb7f4a80401b96748d09_1451887394_25.JPG

본문
유인균(유익성 인체 균)의 중요성은 당을 분해하여 글루코스 영양소로 발효 전환하는 작용이다. 글리코 영양소 글루코 영양소는 같은 말이다.
글루코영양소는 글루코오즈, 갈락토오즈, 만노즈, 퓨코즈, 자일로오즈, N-아세틸 글루코사민, N-아세틸 갈락토사민, N-아세틸 뉴라민산 등 다양하며
설탕과 과일이나 채소 산야초를 혼합하여 발효하면 글루코 영양소로 전환된다.
최근 Science, Nature 지에 글루코영양소가 소개되었고 미국 NBC방송국을 통해 전 세계적으로 급속히 전파되고 있는 세포가 필요로 하는
필수 영양소를 미국 MIT공대에서 향후 인류문화를 리드해 나갈 10대 기술 중 하나로 "글리코믹스"를 체택했다.
향후 생산되는 모든 의약품은 글리코 영양소를 기본 기전으로 "글리코믹스"를 통한 고성능 신약개발을 위해 산업자원부 차세대 신기술사업으로
1차 235억원 투입되어 연구수행기관-한국생명공학연구원이 진행했다.
한국의과학연구원은 한국생명공학연구원 BVC센터내있는 연구소로 글루코영양소를 쉽게 전환 획득하는 미생물 기술기반 데이터베이스를
구축하는 연구를 수행하고 있다.
당 섭취가 매우 높은 현대인들은 당을 분해할 수 있는 장내 유익성 인체균의 비율이 높은 상태를 유지하는것이 매우 중요하다.
우리몸에는 확실히 파악할 수 없는 다수의 미생물이 있으나 그 대부분은 기회를 엿보는 성질을 지니고 있어서 세력이 강한 우두머리격의
소생형 또는 붕괴형 유인균 미생물의 경향대로 따라간다.
소생형이 될지 붕괴형이 될지는 얼마 안 되는 우두머리격 미생물 공존공생력으로 뭉친 유해성으로 이끌어 유인하는 유인균 또는 유익성으로
이끌어 유인하는 유인균들이 장악하고 있다.
소생형 유인균은 발효전환 붕괴형 유인균의 독소는 부패 전환 하는 이들이 세력투쟁을 전개하여 어느 쪽인가가 이기면 몇 조나 되는
다른 미생물들은 승자가 하는 대로 따라간다.
인간의 장 내부에도 비슷한 상황이 전개되는데 인간의 장 내부에는 4000종류 이상 미생물이 100조마리 무게는 2kg 이나 살고있다.
항상 세력투쟁을 하고 있는 것은 발효 유인균과 부패 유인균으로 구분되며 나머지 몇조나되는 균은 모두 기회를 엿보는 세균들이다.
따라서 우리들이 유익성 발효 우두머리격의 소생형 유인균을 먹으면 대체로 뱃속 상태가 유지되도록 되어 있어 4000종류 100조마리의
균 하나하나에 신경 쓸 필요는 전혀 없다.
소생형 유인균 미생물의 대표적인 미생물에게 좋은 환경조건을 부여해서 번식시켜 주면 그 방향성에 다른 균들도 모두 따라오는 성질을
가지고 있다.
장내 유익성 세균의 세력들은 섭취한 당을 분해하여 인체 세포가 절대적으로 필요한 글루코영양소(글루코영양소)를 만들어 준다.
유해성 균들이 많으면 당을 부패시켜 당 독소로 전환하고 인체는 당을 분해하기 위하여 인체 뼈의 미네랄을 녹여 사용하기 때문에
심각한 질병의 위험이 높아진다.
장내 세균의 유익성 인제 미생물은 당을 분해하여 글루코영영소로 전환해준다. 글루코영양소는 세포간의 대화와 면역기능을 증진시킨다.
한국의과학연구원 당화균인 고초균 작용
설탕과 매실을 반반 넣어서 만드는 매실 효소액(매실 발효액)은 유익성 유인균 미생물을 넣어서 발효를 해주면 이당류의 설탕과 매실 영양분이
유익성 유인균 미생물들의 발효전환 작용으로 당이 글루코영양소로 전환된다. 또한 매실 과육과 매실 씨앗의 독소인 시안배당체역시 분해되어 사라진다.
미생물을 넣어주지 않는다면 매실설탕절임 이지만 미생물을 넣고 매실반 설탕반을 넣어 발효한 것은 글루코영양소 매실 발효액이 되어 건강에 도움이 된다.